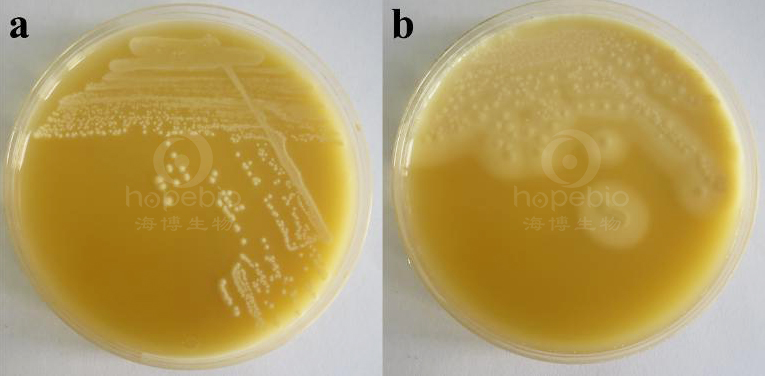

海博微信公众号
海博微信公众号
 海博天猫旗舰店
海博天猫旗舰店


 海博微信公众号
海博微信公众号
 海博天猫旗舰店
海博天猫旗舰店




用途:用于肉毒梭菌、产气荚膜梭菌的分离培养。
原理:蛋白胨、牛肉粉提供氮源和维生素,葡萄糖提供碳源,氯化钠维持均衡的渗透压,卵黄中含有卵磷脂,含有卵磷脂酶的细菌可分解卵磷脂,在培养基周边生成不溶性的、不透明的浑浊带,琼脂是培养基的凝固剂。
操作步骤:
使用前,把制备好的平板放置室温10-20分钟。
1、制备质控菌液。
2、将质控菌液划线于平板上。
4、36±1℃倒置培养基厌氧培养18-24小时,记录实验结果。
微生物试验:
接种以下质控菌株,36±1℃倒置培养基厌氧培养18-24小时:

方法的局限性
本培养基仅为细菌鉴定的一部分,需做其他补充试验。
图1-2 卵黄琼脂培养基微生物质控结果
备注:a: 金黄色葡萄球菌,b:产气荚膜梭菌
相关产品:
注:本文属海博生物原创,未经允许不得转载。
上一篇:察氏琼脂原理及现象
下一篇:R2A琼脂培养基的原理及应用



